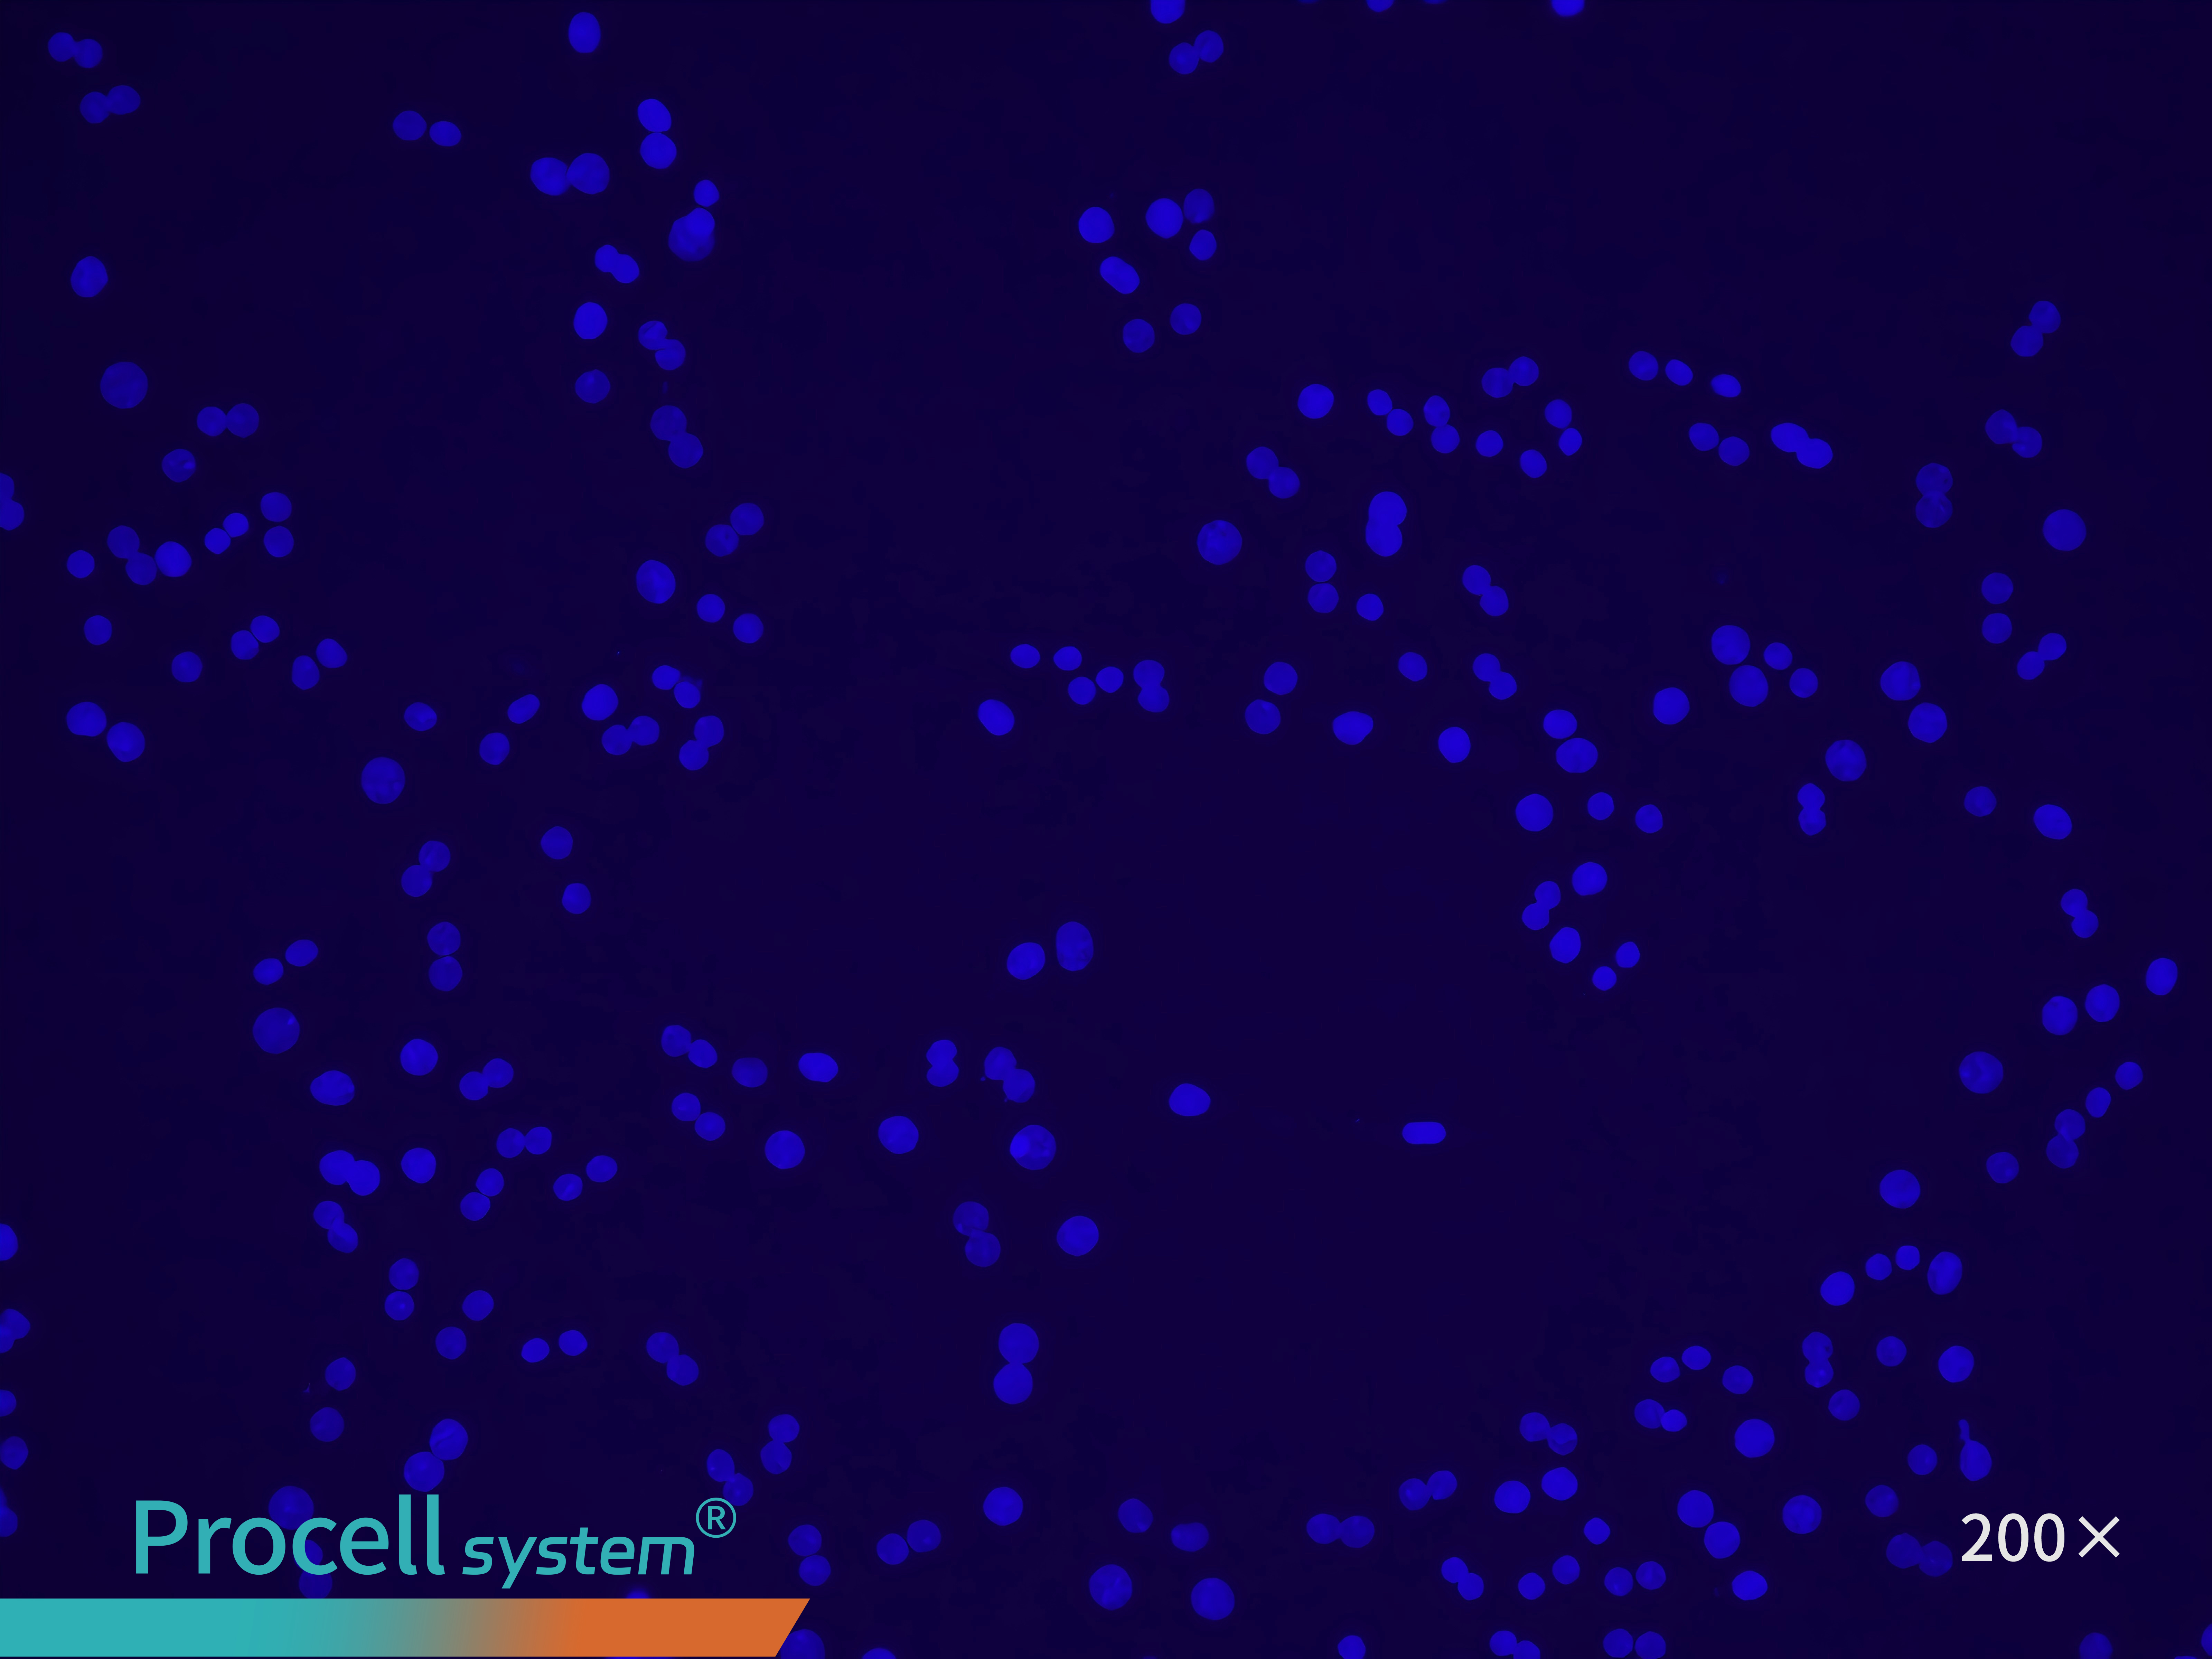
DAPI

Optimized Protocols for Hepatic Parenchymal Cell Isolation, Culture, and Model Development
Jan 13,2026
Hepatic parenchymal cells are the primary functional cells of the liver and a cornerstone of hepatic research. As highly differentiated cells, they preserve key metabolic enzyme activities and physiological functions observed in vivo, making them indispensable for injury modeling, drug toxicity evaluation, and studies of liver regeneration.
Despite their broad utility, the efficient and reproducible isolation of hepatic parenchymal cells with high purity and viability remains technically challenging due to the structural complexity of liver tissue and the presence of multiple non-parenchymal cell types. In addition, hepatic parenchymal cells are highly sensitive to mechanical and chemical stress, which renders isolation procedures technically demanding and prone to experimental variability.
In this issue of Cell Culture Academy, we present standardized, step-by-step protocols for rat hepatic parenchymal cell isolation and culture, along with practical guidance for their application in liver disease models.
I. Basic Information
Cell Name: Rat hepatic parenchymal cells
Tissue Origin: Liver
Cell Description: Hepatic parenchymal cells are the principal functional cells of the liver, playing essential roles in metabolic regulation, detoxification, bile production, and immune modulation. Their functional integrity is critical for hepatic homeostasis. Viral infection, drug exposure, or immune dysregulation can cause hepatic parenchymal cell injury and acute inflammation, while sustained injury activates hepatic stellate cells, promoting extracellular matrix deposition and progression to liver fibrosis and cirrhosis.
Cell Characteristics: Hepatic parenchymal cells are moderately to highly differentiated cells with minimal proliferative capacity and are not amenable to passaging. They require nutrient-rich conditions and exhibit limited viability in vitro.
Ⅱ. Operational Procedures
1. Perfusion Digestion
Anesthesia and Fixation: Sprague-dawley, Wistar-imamichi, or other rat strains (14-56 days) are anesthetized, disinfected, and secured on a dissection board.
Anatomy: Make a transverse incision and bluntly dissect the subcutaneous tissue to expose the abdominal cavity and liver.
Perfusion:
Two options are available: peristaltic pump-assisted or manual perfusion.
Option 1. Peristaltic Pump Perfusion
Cannulation: Expose the inferior vena cava and portal vein. Insert a perfusion needle into the inferior vena cava and connect it to the pre-perfusion solution.
Pre-perfusion: Pump at 20 mL/min until the liver becomes fully distended; incise the portal vein to allow outflow until the liver tissue turns waxy yellow.
Enzymatic Digestion: Switch to the digestion solution, perfuse at 10 mL/min for 10-20 min, and gently compress the portal vein. Completion is indicated by fissure-like striations on the liver surface.
Option 2. Manual Perfusion
Prepare two syringes containing the pre-perfusion and digestion solutions.
Cannulate the inferior vena cava and perform pre-perfusion as described above.
Replace the syringe with digestion solution and perfuse following the same procedure.
After perfusion digestion, excise the liver, transfer it to washing solution, remove the capsule and gallbladder, and gently agitate to release hepatic parenchymal cells.
2. Isolation and Purification
Filter the cell suspension sequentially through 100 μm and 70 μm strainers. Centrifuge at 50 g for 5 min, discard the supernatant, and wash/resuspend cells 2-3 times. Assess viability using Trypan Blue Solution.
3. Cell Culture
Coat the culture dish: Incubate at 37℃ for more than 2 h, or coat overnight at 4℃.
Inoculate at a viable cell density of 3×105 cells/cm² in attachment medium.
After 4-6 h, Hepatic parenchymal cells appear large, round, and often binucleated. Replace with maintenance medium.
Hepatic parenchymal cells typically begin to dedifferentiate after 24 h, showing irregular morphology and loss of characteristic features.
For detailed procedures, refer to the official Rat Hepatic Parenchymal Cell Isolation and Culture Kit instruction manual.
III. Cell Characterization
1. Morphology
Under the microscope, hepatic parenchymal cells appear round or polygonal with large, centrally located nuclei; some cells display binucleation or polyploidy.
2. Marker Analysis
Immunofluorescence staining for the hepatic parenchymal cell-specific marker Cytokeratin-18 confirms cell purity of 90% (Figure 1).
Figure 1. Immunofluorescence identification of rat hepatic parenchymal cells
IV. Culture Conditions
Culture Medium: Rat Hepatic Parenchymal Cell Complete Medium
Medium Change Frequency: Every 2-3 days; cells remain viable for ~1 week
Morphology: Adherent, epithelial-like cells
Passage Characteristics: Non-proliferative; use immediately for experiments
Digestion: Enzymatic treatment is not recommended
V. Applications
1. Alcoholic Liver Disease (ALD)[1]
Principle: Ethanol, LPS, and palmitic acid (PA) induce hepatic parenchymal cell steatosis, oxidative stress, and inflammation, modeling alcoholic liver injury phenotypes.
Methods:
Monoculture: Hepatic parenchymal cells are cultured with 1-5 mg/mL ethanol and 400 μM PA for 24 h to induce steatosis.
Coculture: Hepatic parenchymal cells are cocultured with hepatic stellate cells under dynamic/rotational conditions to mimic the liver microenvironment and tissue repair.
Microfluidic Chip: Hepatic parenchymal cell-hematopoietic stem cell spheroids exposed to ethanol-containing medium to generate an inflammation-enhanced ALD model.
2. Non-Alcoholic Steatohepatitis (NASH)
Principle: High glucose, free fatty acids (FFA), and LPS induce steatosis, inflammation, and fibrosis.
Methods:
Monoculture: Hepatic parenchymal cells are cultured in high-glucose medium to induce lipid accumulation.
Coculture: Hepatic parenchymal cells cocultured with hepatic stellate or hematopoietic stem cells under high-glucose, high-fat, TGF-β, or LPS conditions to model fibrosis and advanced disease[2].
Organoids: Scaffold-free coculture of hepatic parenchymal cells, stellate, and liver endothelial cells generates hLiMTs organoids. Organoids are maintained in high-glucose, FFA, and LPS medium to model steatosis, inflammation, and fibrosis[3].
3. Drug-induced Liver Injury (DILI)
Principle: DILI involves complex metabolic and immune mechanisms.
Methods:
Dose-dependent Models: Repeated exposure to acetaminophen or methotrexate induces hepatic parenchymal cell loss.
Immune-Related Toxicity Models: Coculture with non-parenchymal cells ensures long-term stability.
3D Liver Tissue: Hepatic parenchymal cells are seeded on culture inserts under air-liquid interface (ALI) to form 3D liver tissue for evaluating complex drug responses.
References
[1]Zhu L, Li HD, Xu JJ, et al. Advancements in the alcohol-associated liver disease model. Biomolecules. 2022 July 27; 12 (8): 1035.
[2]Kostrzewski, T., Snow, S., Battle, A.L. et al. Modelling human liver fibrosis in the context of non-alcoholic steatohepatitis using a microphysiological system. Communications Biology. 2021 September 15;4 (1): 1080 .
[3] Ströbel S, Kostadinova R, Fiaschetti-Egli K, et al. A 3D primary human cell-based in vitro model of non-alcoholic steatohepatitis for efficacy testing of clinical drug candidates. Scientific Reports. 2021; 11 (1): 22765.
[4] Holm C, Finelli J, Frare M, et al. Bioengineering of novel organotypic 3D human liver tissue model for drug-induced liver injury and toxicity studies. Frontiers in Toxicology. 2025 June 12; 7: 1574387.
[5] Guo H, Urban S, Wang W. In vitro cell culture models to study hepatitis B and D virus infection. Frontiers in Microbiology. 2023 April 5; 14: 1169770.
Prev: Key Tips for Isolating Rat Pulmonary Great Artery Endothelial Cells
Next: Overcoming Low Transfection Efficiency in THP-1 Cells Through mRNA Delivery